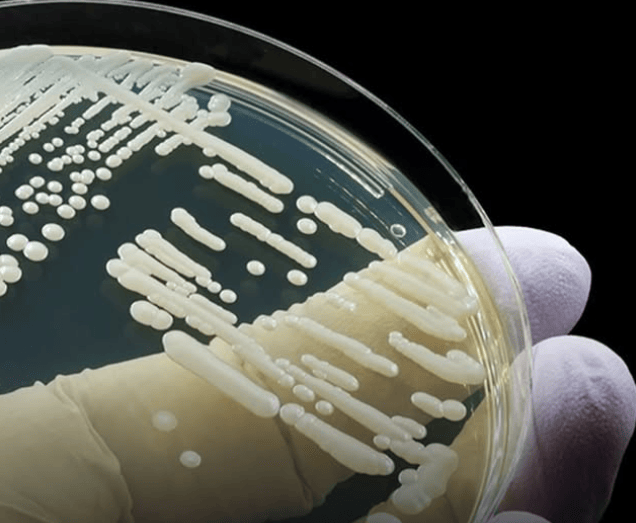

Filipe Luís tornou-se o principal destaque entre os técnicos brasileiros neste ano. Aos 40 anos, assumiu o Flamengo de forma meteórica em setembro de 2024, conquistando...



A embarcação Global Sumud Flotilla, que transportava a deputada federal Luizianne Lins (PT) e outros ativistas pró-Palestina, incluindo brasileiros, foi interceptada pelas forças armadas de Israel...

Um alerta de saúde foi emitido na Europa devido à rápida disseminação do fungo Candidozyma auris, que apresenta resistência a medicamentos e tem causado preocupação entre...



As menores temperaturas em 25 anos foram registradas pelos termômetros suecos na última quarta-feira (3), atingindo um frio de -45ºC. O ápice dessa baixa temperatura, chegando...



O aplicativo foi acusado de coletar dados de cidadãos americanos e influenciar usuários com conteúdo pró-China. Com reforço no lobby e mudança de processo, o problema...



Na quinta-feira (29), a sonda Juno, da NASA, voou a 300 km da superfície de Europa, uma das quatro maiores luas de Júpiter (que tem, ao...



O Reino Unido chegou nesta terça-feira (19) à maior temperatura da sua história, em meio a uma das piores ondas de calor na Europa na última...


A Polícia Federal (PF) realiza uma operação nesta quarta-feira (13) contra uma organização criminosa especializada no tráfico internacional de drogas e lavagem de dinheiro nos terminais...



Um relatório da Fundação Oswaldo Cruz (FioCruz) no Ceará identificou que o estado possui a presença de sublinhagens mais transmissíveis da variante ômicron do coronavírus. O...


Os governos europeus deveriam lidar com as consequências econômicas da guerra na Ucrânia por meio da política fiscal, para permitir que a política monetária se normalize...



No início de 2022, a eleição presidencial da França prometia ser uma das corridas políticas mais emocionantes do país em décadas. Um presidente em exercício, procurando...


O Conselho da Europa expulsou ontem (16) a Rússia do principal órgão de direitos humanos do continente, devido à invasão e guerra na Ucrânia, numa ação...


A partir de R$ 5. Esse é o preço comum de venda da jaca nos mercados e mercantis brasileiros. Mas, e na Europa, por qual razão...
O homem moderno pode ter chegado à Europa bem antes do que se pensava, inclusive coexistindo com os neandertais (Homo neanderthalensis) da época, de acordo com...